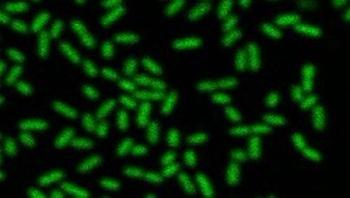

Sterile Processing
Latest News




When assigning blame for a number of outbreaks linked to contaminated and improperly processed duodenoscopes, a U.S. Senate report released in January pointed equally to hospitals, scope and equipment manufacturers and the Food and Drug Administration (FDA) for failing to act on known risks of infection. Duodenoscopes have been implicated in at least 250 patient infections with carbapenem-resistant enterobacteriaceae (CRE) between 2012 and the spring of 2015.







In light of the recent news articles making headlines across the country in regard to improperly sterilized reusable medical devices, the issue of requiring certification of Central Service (CS) technicians has become more important than ever.

Q: Recently we had a consultant visit our department. She said I was performing the Bowie-Dick test wrong. I place the test pack on top of a wire basket which is placed over the drain line. This is how I was shown to do the test and we all do it the same way. The consultant could not explain why this is wrong. Can you explain the correct process and why?
Suicide allows bacteria found in opportunistic infections to create an antibiotic tolerant biofilm, according to a team including researchers at Rensselaer Polytechnic Institute (RPI). In work recently published in Current Biology, the researchers found that a molecule secreted by the bacterium Pseudomonas aeruginosa causes a breakdown in the respiratory chain, killing some of the population and triggering the creation of a biofilm among survivors, and thus conferring increased tolerance to antibiotics.








Rice University students and their mentors have created a sterilization station for surgical instruments that can help minimize risk of infections to patients anywhere in the world.





